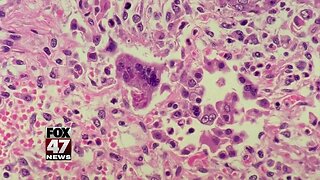

Premium Only Content
This video is only available to Rumble Premium subscribers. Subscribe to
enjoy exclusive content and ad-free viewing.

Measles warning issued for Disneyland in California
5 years ago
8
Viral
Measles
Warning
Issued
Disneyland
California
Los Angeles
Department
Public Health
Person
Infected
According to the Los Angeles Department of Public Health, a person infected with the disease visited the park.
Loading comments...
-
1:38
1:38
WSYM
6 years agoMeasles quarantine issued at two California universities
4 -
 2:18
2:18
KTNV
6 years agoMeasles warning issued after adult diagnosed in Las Vegas
10 -
 1:15
1:15
KGUN
6 years agoTornado warning issued In Pima County
49 -
 0:29
0:29
WMAR
6 years agoMeasles warning in Maryland
8 -
 0:20
0:20
KGTV
5 years agoCalifornia launching early earthquake warning system
42 -
 2:06
2:06
WEWS
6 years agoSevere Thunderstorm Warning issued for multiple counties
4 -
 1:10
1:10
CoverVideo
6 years ago $0.01 earned'Zombie' deer warning is issued for Nevada hunters
27 -
 1:32
1:32
KNXV
6 years agoHeat warning issued Sunday around the Valley
25 -
 0:25
0:25
KGTV
5 years agoDisneyland guests warned of measles exposure after infected person visits park
7 -
 1:54
1:54
WXYZ
6 years agoNew warning issued about car-wrap advertisement scheme
32